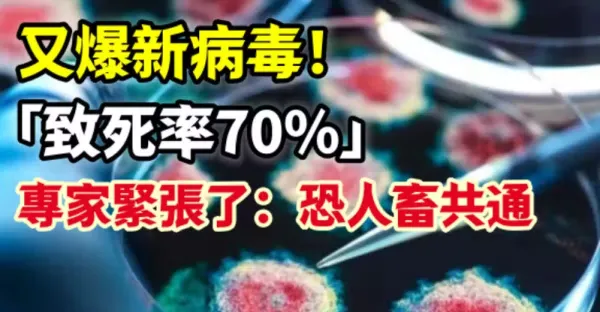

花伊風 • 280次觀看

花伊風 • 90次觀看

許夢可 • 3K次觀看

喬峰傳 • 15K次觀看

劉奇奇 • 430次觀看

劉奇奇 • 560次觀看

劉奇奇 • 2K次觀看

劉奇奇 • 2K次觀看

許夢可 • 1K次觀看

呂純弘 • 270次觀看

喬峰傳 • 910次觀看

孫毅枝 • 4K次觀看

許夢可 • 4K次觀看

許夢可 • 1K次觀看

劉奇奇 • 410次觀看

劉奇奇 • 470次觀看

劉奇奇 • 240次觀看

劉奇奇 • 720次觀看

許夢可 • 10K次觀看

徐程瀅 • 290次觀看

許夢可 • 2K次觀看

徐程瀅 • 640次觀看

呂純弘 • 870次觀看

呂純弘 • 4K次觀看